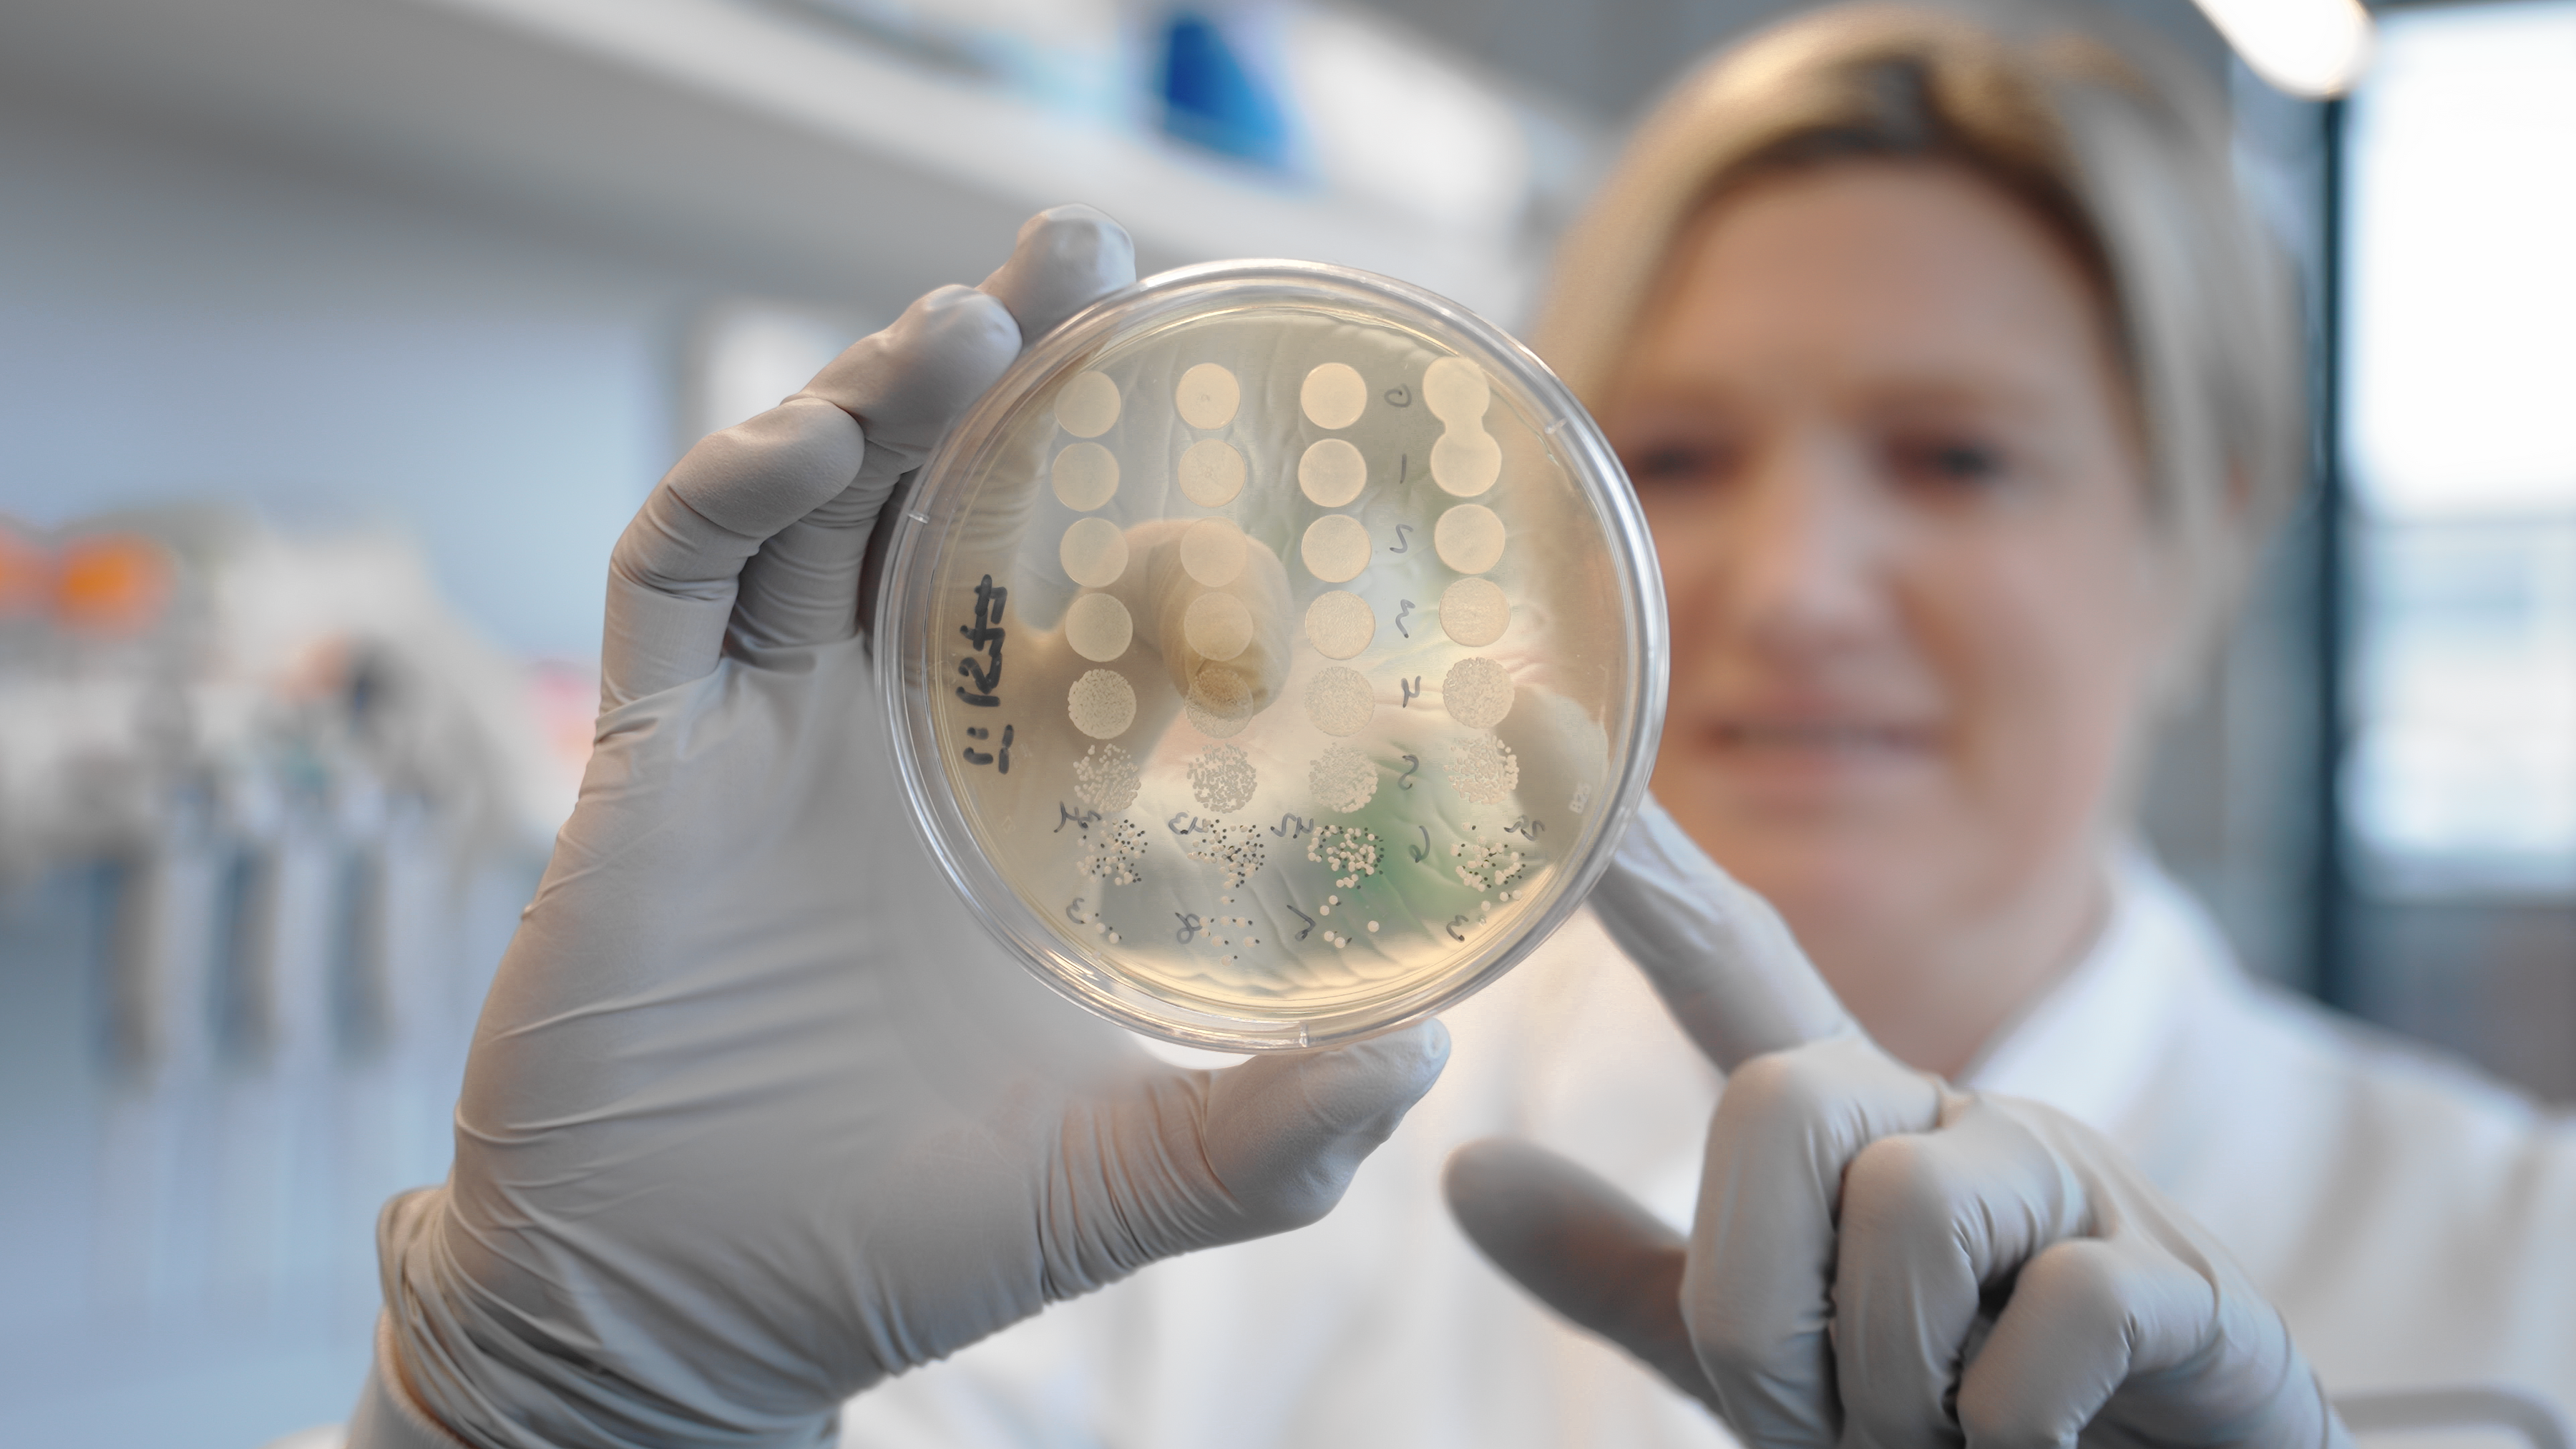

Welcome to TRUESHOT FILMS!
Premium Corporate & Agency Video Production in Boston & Metrowest — Videos that boost campaigns, conversions, and brand credibility.

Event Coverage

Marketing & Campaign Videos

Case Studies
Product & Demo Videos

Corporate Brand Films

Drone Footage

Internal Communications & Training

Agency Production Support
